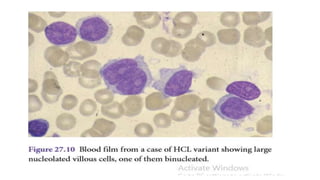
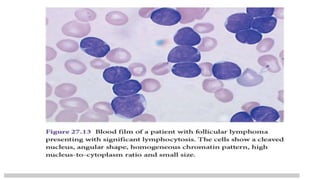
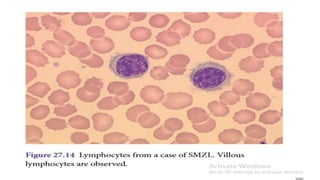

This document discusses several B cell disorders other than chronic lymphocytic leukemia (CLL) that can involve the blood and bone marrow. These include non-Hodgkin's lymphomas like mantle cell lymphoma, lymphoblastic lymphoma, and marginal zone lymphoma that may present similarly to CLL. It also describes disorders like hairy cell leukemia, lymphoplasmacytic lymphoma, and splenic marginal zone lymphoma that commonly involve the blood. Key diagnostic features of these various disorders are outlined.